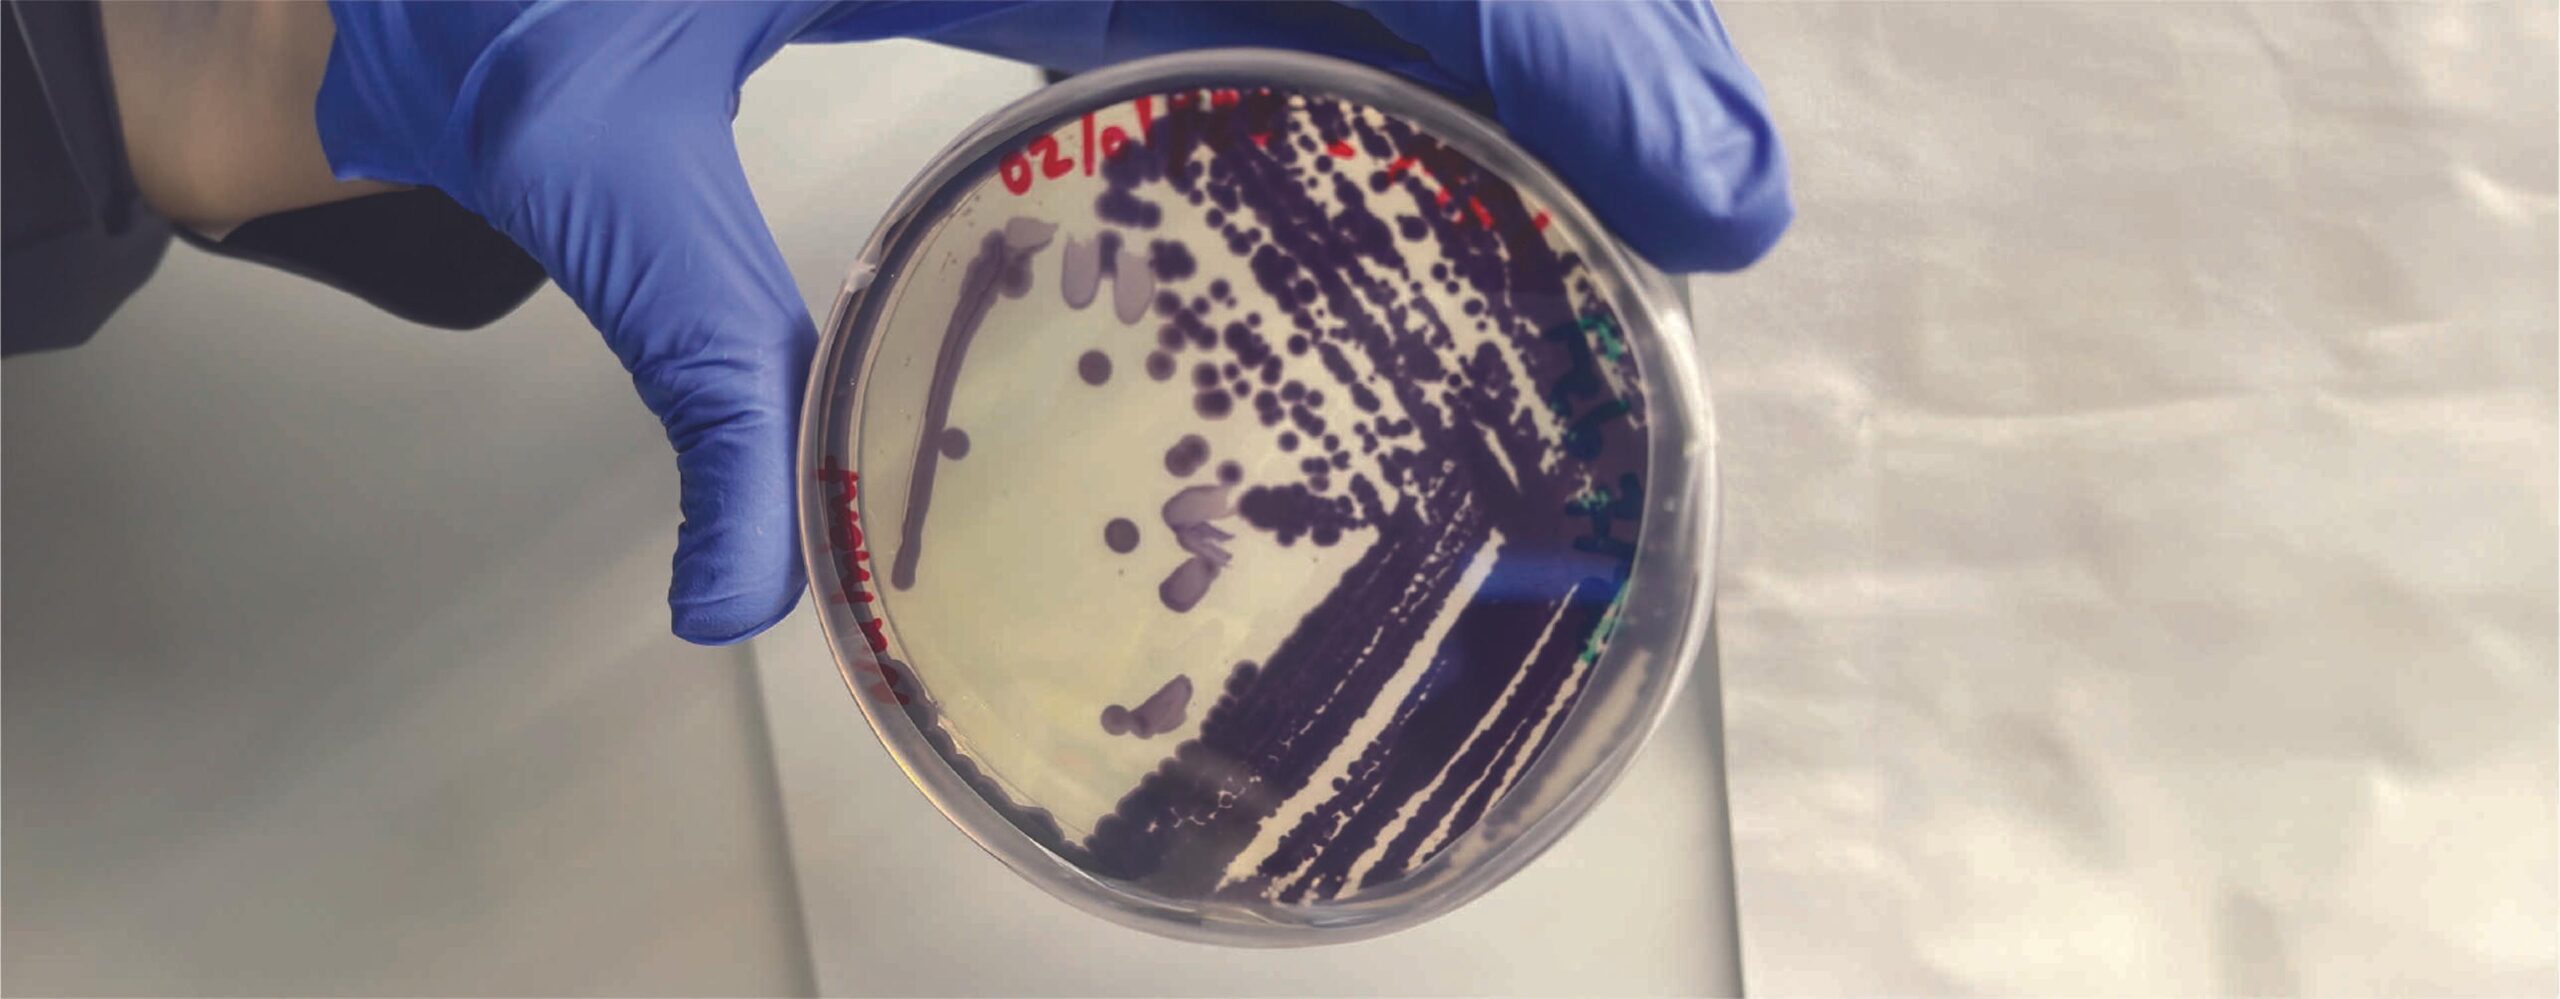

These Alternative Food Coloring Startups Are Set To Win Big With FDA’s Ban on Red Dye No. 3
The US Food and Drug Administration has banned Red Dye No. 3 after it was found to cause cancer in rats – a positive move for food safety, and alternative food coloring brands.
Candy corn, gummy bears, cough syrups and vegan bacon are all under threat, with the US banning a popular red food dye derived from petroleum.
The Food and Drug Administration (FDA) has revoked its authorisation for Red Dye No. 3 in response to a 2022 petition, decades after it entered the food system. At least two studies have shown high intakes of the color additive to cause cancer in male rats, although that link hasn’t appeared in humans. And in any case, typical exposure levels for humans are far below the thresholds seen in lab studies.
However, the FDA’s Delaney Clause – which prohibits additives that cause cancer in humans or animals – has a zero-tolerance stance for carcinogens, forcing the agency’s hands on the ban of the synthetic dye.
Already prohibited (or at least severely restricted) in Europe, Japan, Australia and New Zealand, the US ban has been long overdue. The colorant’s use in cosmetics has been outlawed in the US since 1990, but people have been calling on the agency to extend this to food for decades.
Pressure has increased recently as food safety advocates petitioned the government to enact the ban in 2022 and the state of California enforced its own ban last year. With Robert F Kennedy potentially becoming health secretary, there will be a magnified focus on synthetic and ultra-processed foods, so this could be a precursor of things to come.
Today is the one-year anniversary of when we sent our petition to the FDA urging them to finally ban the food dye Red 3! One year on, and the FDA still hasn’t come to a decision or responded to our petition. We’re about to give the FDA a big stack of reminders! pic.twitter.com/ay7n6aox23
— Center for Science in the Public Interest (@CSPI) November 15, 2023
Chemically known as erythrosine, Red Dye No. 3 is manufactured by the iodination of fluorescein, the condensation product of resorcinol and phthalic anhydride. It has no nutritional value, but is used to give a bright-red hue to popular foods, commanding a $43M market.
You’ll find it in products like Pillsbury’s Funfetti cake mixes, Nesquik strawberry milk, Abbott Nutrition’s Ensure milkshakes, Vigo saffron yellow rice, and Morningstar Farms’s vegan bacon.
The move also puts a spotlight on Red 40 (or Allura Red), the most commonly used food coloring in the US. Commanding a $140M market, it’s also made from petroleum (via a chemical reaction between two types of sulphonic acids) and has been linked to hyperactivity in children and cancer in animals. The EU has required manufacturers to put warning labels on products containing Red 40 since 2010.
This FDA ban will force companies to reformulate their products and move to alternative dyes by January 15, 2027 – and while some could choose to use Red 40, the question marks over its safety make more natural colorings like beet juice and paprika extract more favourable.
The ban opens up the market for startups making alternative food dyes with plants, algae and fermentation, free from fossil fuels or animals. The food tech companies now have a significant opportunity to capitalise on the $3.1B global food dye market. Below we list out the main players in the burgeoning space.
Chromologics
Headquarters: Denmark
Founders: Gerit Tolborg and Anders Ødum
Funding: $12.7M

Backed by big-name VCs, Ozempic maker Novo Nordisk, and the Danish government, Chromologics uses precision fermentation to develop its bio-based colorants. It leverages fungi strains to create an alternative to carmine, the red pigment made from crushed beetles and cochineal insects.
It ferments fungus with sugar and other nutrients submerged in water. The microbes produce the red colour during the process, and Chromologics can operate a circular system by recycling the water and using green energy for its fermentation runs. The end product, called Natu.Red, is tasteless, odorless and stable across a wide temperature range.
Phytolon
Headquarters: Yokneam Illit, Israel
Founders: Halim Jubran and Tal Zeltzer
Funding: $18.6M

Israel-based Phytolon has been around since 2018, and also leverages precision fermentation technology to make food dyes. By fermenting baker’s yeast, it produces betalein pigments – typically sourced from agricultural crops like beetroot, cactus fruit and pitaya.
Phytolon’s portfolio for the food and beverage market includes multiple hues, including the red spectrum, making it a planet-friendly alternative to the carbon-heavy Red Dye No. 3 across bakery, savory, frozen, dairy and confectionery applications.
Michroma
Headquarters: Rosario, Argentina and San Francisco, California
Founders: Ricky Cassini and Mauricio Braia
Funding: $6.4M

Another precision fermentation startup, Michroma is backed by the likes of General Mills, Dr. Oatker, and CJ CheilJedang. It uses filamentous fungi strains to produce colors when fed with low-cost feedstocks in bioreactors. The microbes secrete the colors into the media where it grows, which is filtered, dried and concentrated into a final product.
Its dyes have a high protein content with all essential amino acids and fibre, making it an ideal ingredient for plant-based meat, as well as drinks, sweets, gummies, yogurts and baking mixes. Michroma’s Red+ ingredient is stable across a full range of pH and at high temperatures too, and is positioned as a premium, clean-label colorant.
Exberry
Headquarters: Dallas, North Carolina
Parent company: GNT Group
Funding: Undisclosed

Not exactly a startup – but GNT Group’s flagship brand Exberry is sure to benefit from the FDA red dye ban. It makes colorants from fruits, vegetables, and plants, which can be used in soft and alcoholic beverages, confectionery, bakery, dairy, savory, snacks, plant-based meat, and pet food.
Exberry’s portfolio of red colorants can be found in liquid, powder and micronized powder formats, and are made from ingredients like black currants, sweet potatoes, black carrots, or radishes. Some of them contain natural anthocyanin pigments, which offer heat and light stability. Exberry also makes tailormade blends of raw materials to suit different needs, like beetroot and paprika concentrates containing betanin and carotenoid pigments.
Vetik
Headquarters: Kudjape, Saare County, Estonia
Founders: Tanel Ilmjärv and Valmar Kasuk
Funding: €787,000

Vetik is solving several problems at once. It has developed a way to valorise marine algae while producing natural food colorants and crop biostimulants.
The startup has access to a wild red seaweed called Furcellaria lumbricalis – located in the sea area of the West Estonian Archipelago, between two of the country’s biggest islands – which has been harvested in Estonia since 1960 without any detectable effect on raw stock.
Vetik produces chemical-free biostimulants to enhance soil health, plant resilience and growth, and nutrient uptake from both seaweed juice and the leftover pulp. The process also leaves sidestream seaweed solids for testing in various applications, and red pigments for use in food and cosmetics.
Material Futures Lab
Headquarters: Kitchener, Canada
Founders: Iris Redinger
Funding: Undisclosed
Material Futures Lab is another startup tackling food waste and sustainable dyes. It employs a process that transforms genetically modified microorganisms to produce natural colourants from waste, for industries including food, textiles, beauty and homecare.
By isolating microorganisms from natural sources, the firm optimises the production of colourants in microbial hosts. Its dyes are stable across a range of pH levels and don’t fade in clear packaging. The synbio startup can create colours across the spectrum, and says its innovations help reduce the environmental impact of synthetic dyes with a cleaner, scalable alternative.
